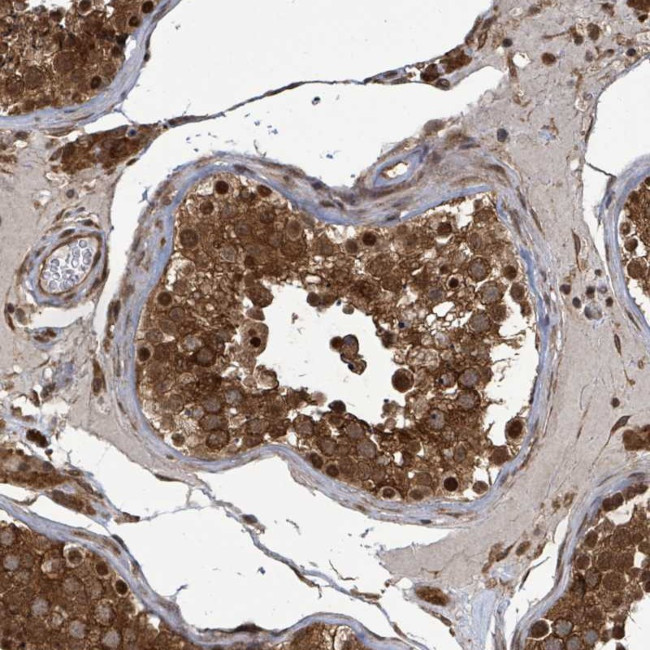
KLC1 Antibody in Immunohistochemistry (Paraffin) (IHC (P))

Search
Invitrogen
KLC1 Polyclonal Antibody
{{$productOrderCtrl.translations['antibody.pdp.commerceCard.promotion.promotions']}}
{{$productOrderCtrl.translations['antibody.pdp.commerceCard.promotion.viewpromo']}}
{{$productOrderCtrl.translations['antibody.pdp.commerceCard.promotion.promocode']}}: {{promo.promoCode}} {{promo.promoTitle}} {{promo.promoDescription}}. {{$productOrderCtrl.translations['antibody.pdp.commerceCard.promotion.learnmore']}}
产品信息
PA5-60780
种属反应
宿主/亚型
分类
类型
抗原
偶联物
形式
浓度
规格
纯化类型
保存液
内含物
保存条件
运输条件
RRID
产品详细信息
Immunogen sequence: STMVYIKEDK LEKLTQDEII SKTKQVIQGL EALKNEHNSI LQSLLETLKC LKKDDESNLV EEKSNMIRKS LEMLE
Highest antigen sequence identity to the following orthologs: Mouse - 97%, Rat - 96%.
靶标信息
Conventional kinesin is a tetrameric molecule composed of two heavy chains and two light chains, and transports various cargos along microtubules toward their plus ends. The heavy chains provide the motor activity, while the light chains bind to various cargos. This gene encodes a member of the kinesin light chain family. It associates with kinesin heavy chain through an N-terminal domain, and six tetratricopeptide repeat (TPR) motifs are thought to be involved in binding of cargos such as vesicles, mitochondria, and the Golgi complex. Thus, kinesin light chains function as adapter molecules and not motors per se. Although previously named "kinesin 2", this gene is not a member of the kinesin-2 / kinesin heavy chain subfamily of kinesin motor proteins. Extensive alternative splicing produces isoforms with different C-termini that are proposed to bind to different cargos; however, the full-length nature of some of these variants has not been determined.
仅用于科研。不用于诊断过程。未经明确授权不得转售。
篇参考文献 (0)
生物信息学
蛋白别名: hKLC1B; hKLC1C; hKLC1G; hKLC1J; hKLC1K; hKLC1N; hKLC1P; hKLC1R; hKLC1S; kinesin 2 60/70kDa; Kinesin light chain 1; Kinesin2; KLC 1; KNS 2; KNS 2A; medulloblastoma antigen MU-MB-2.50; MGC15245; unnamed protein product
基因别名: KLC; KLC1; KNS2; KNS2A
UniProt ID: (Human) Q07866
Entrez Gene ID: (Human) 3831